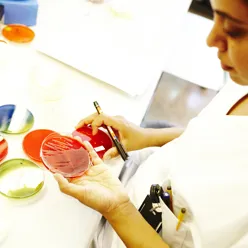
En kvinne som maler en bolle

Forskning er en av sykehusets kjerneoppgaver, og viktig for kvaliteten og sikkerheten i pasientbehandlingen.
Sykehuset i Vestfold har mange etablerte og aktive forskningsgrupper, samt dyktige enkeltforskere som gjennomfører studier og frembringer ny kunnskap innen ulike fagområder. De siste årene har forskningsaktiviteten ved sykehuset vært økende og sykehuset deltar i ulike nasjonale og internasjonale forskningsnettverk og samarbeid.
Forskningsgruppene som er etablert ved Sykehuset i Vestfold:
I tillegg har vi følgende forskningsprosjekter som foregår ved Sykehuset i Vestfold:
Kliniske studier:
Sist oppdatert 02.02.2024